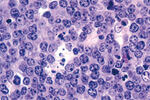
Pridodavanje rituksimaba kemoterapiji produžuje preživljavanje djece s ne-Hodgkinovim limfomom

Redefiniraj pretragu
Pretraživanje
Probojno krvarenje
06.06.2020. 14:45 |
forum/bolesti_i_stanja/kontracepcija/probojno_krvarenje2
Perkutana krioablacija uspješna u liječenju raka bubrega u početnom stadiju
14.06.2020. 11:58 |
vijesti/perkutana_krioablacija_us...ju_raka_bubrega_u_pocetnom_stadiju

Simptomi depresije povezani s većim rizikom od kardiovaskularne bolesti
14.06.2020. 11:39 |
vijesti/simptomi_depresije_poveza...izikom_od_kardiovaskularne_bolesti

Prestanak komzumiranja pilula
14.06.2020. 21:00 |
forum/specijalizacije_medicina/gi...cija/prestanak_komzumiranja_pilula
U posljednja 24 sata dva nova slučaja zaraze novim koronavirusom
15.06.2020. 15:42 |
vijesti/u_posljednja_24_sata_dva_...slucaja_zaraze_novim_koronavirusom

Nocni orgazam kod zena
07.06.2020. 12:05 |
forum/specijalizacije_medicina/gi...pstetricija/nocni_orgazam_kod_zena
Vakcine i alergija
15.06.2020. 16:10 |
forum/bolesti_i_stanja/alergije/vakcine_i_alergija
Osobe koje pate od reumatoidnog artritisa s povećanom aktivnošću bolesti izložene većem riziku od tromboze
07.06.2020. 12:16 |
vijesti/osobe_koje_pate_od_reumat..._izlozene_vecem_riziku_od_tromboze

Lohije
15.06.2020. 22:35 |
forum/specijalizacije_medicina/ginekologija_i_opstetricija/lohije